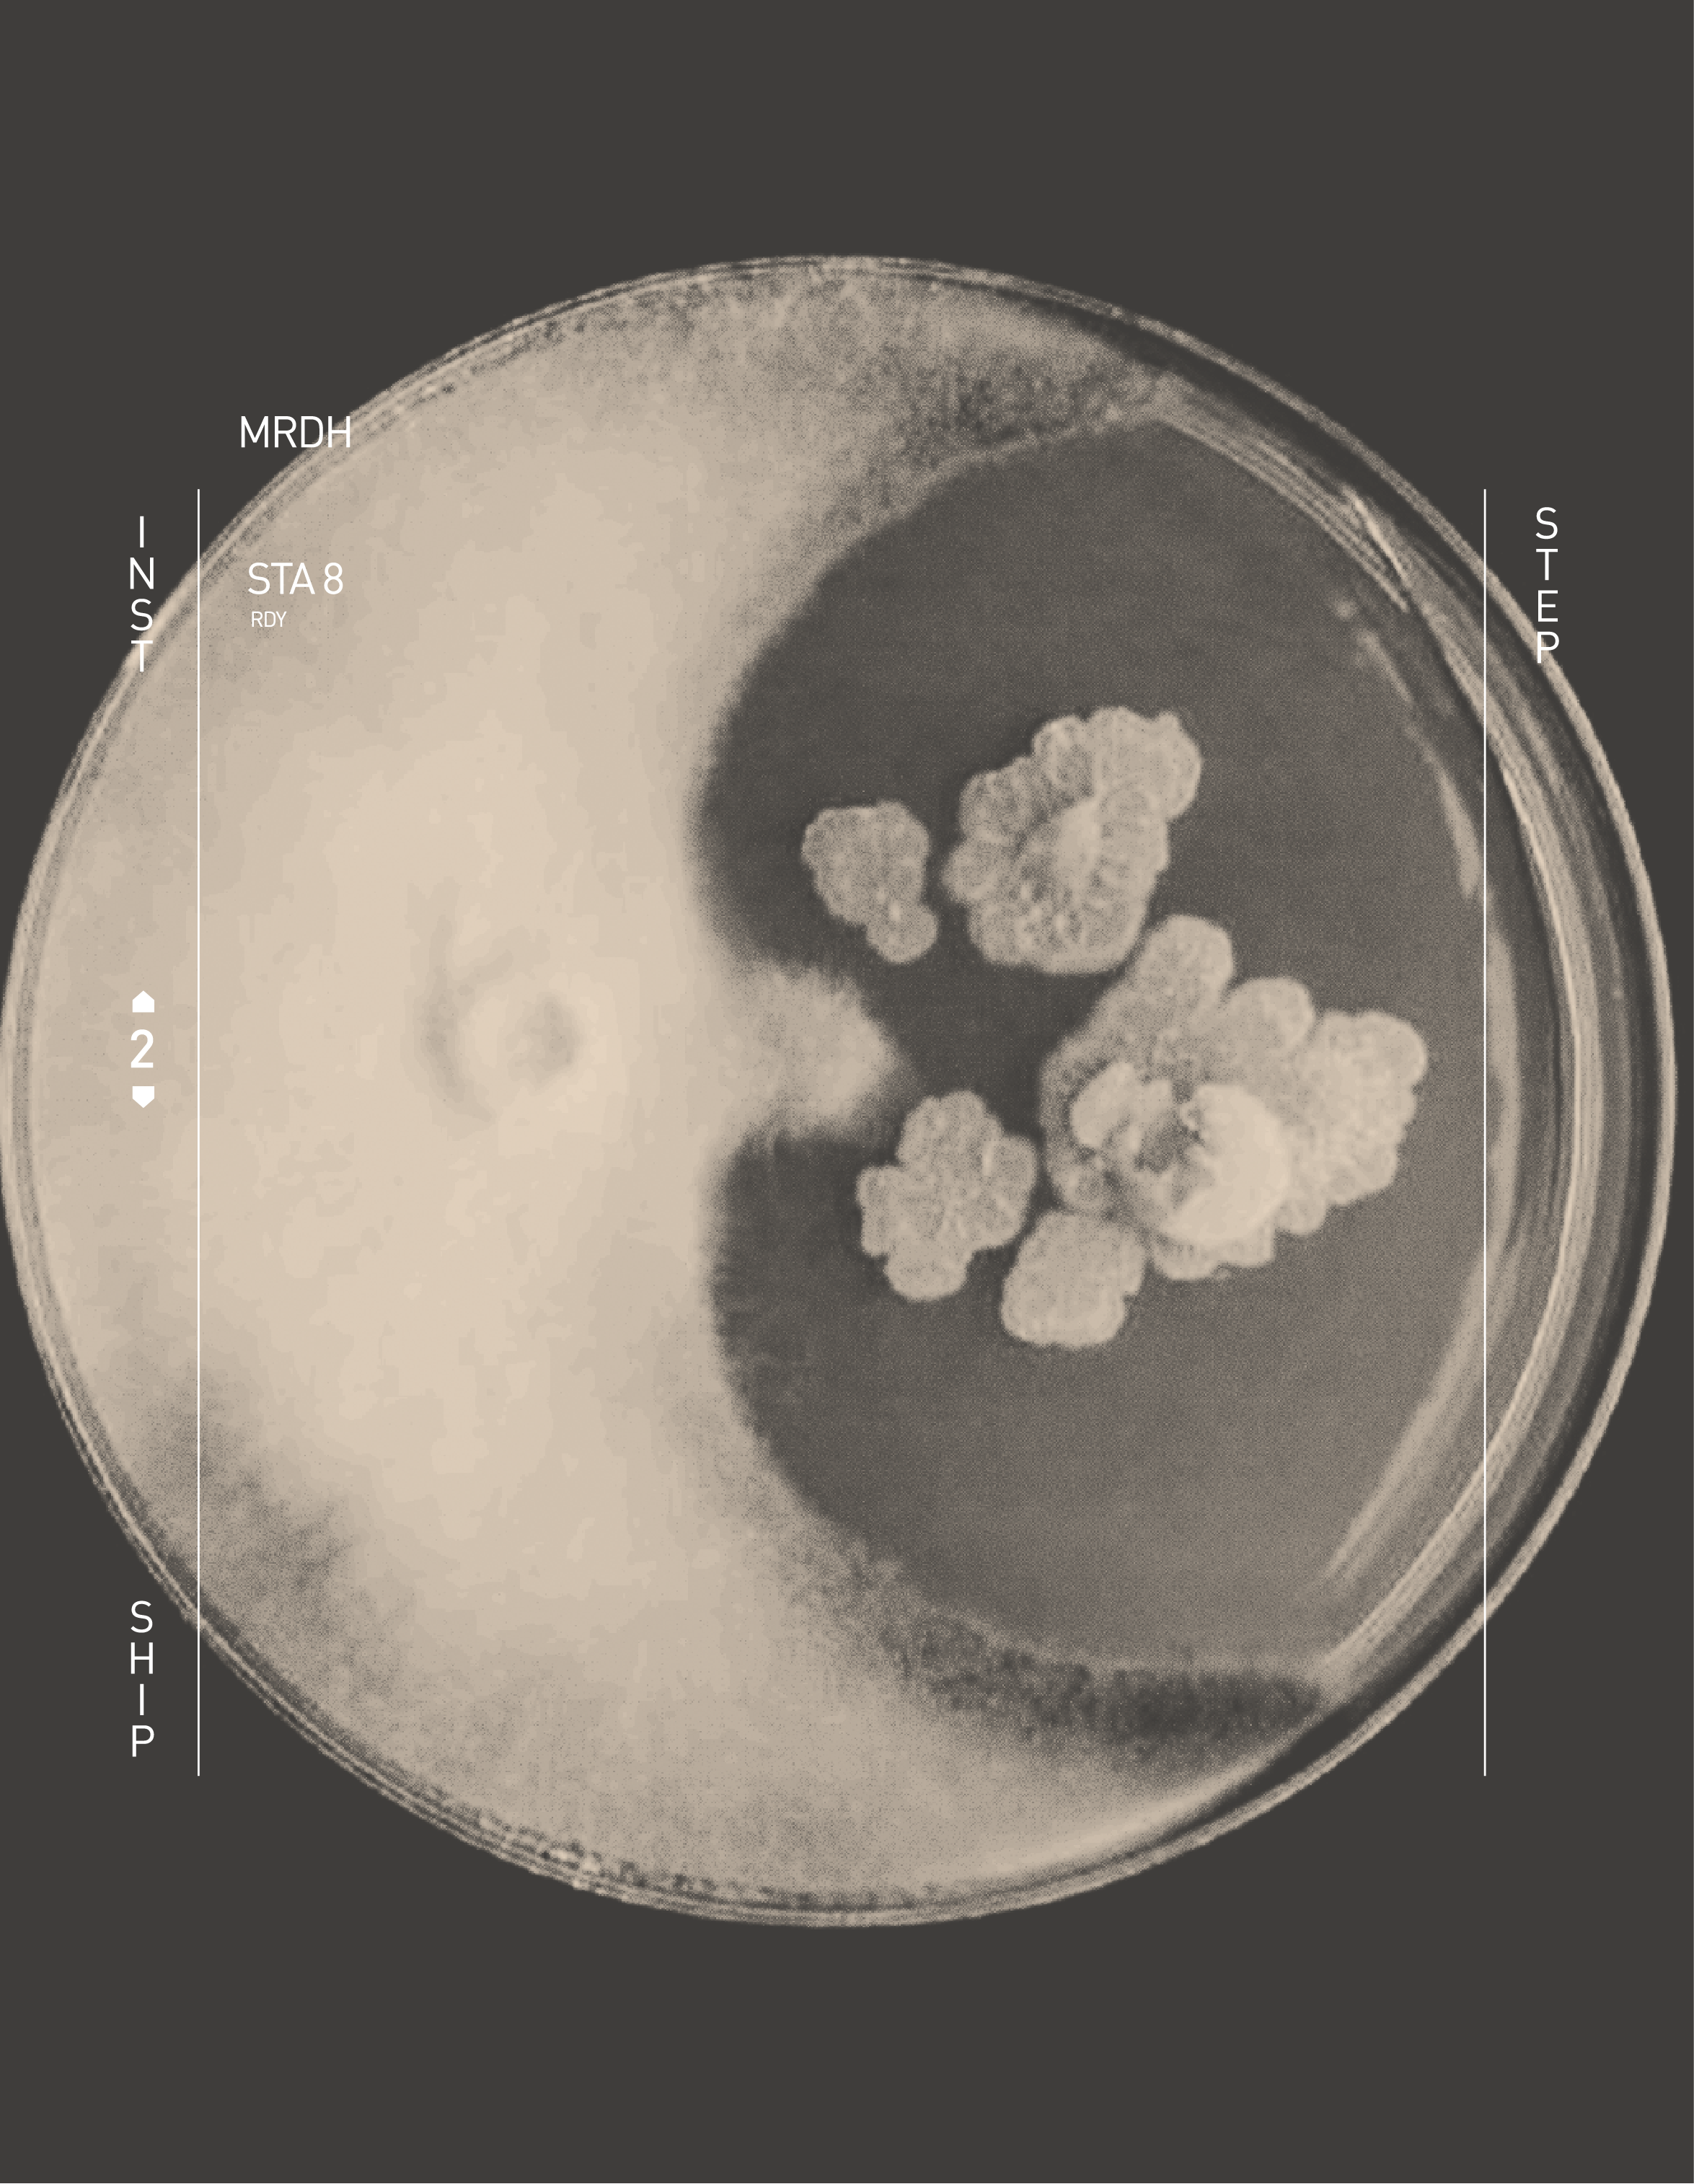

Museo ruinas de Huanchaca
Sala de patrimonios
Patrimonio Biológico
Biotecnología
Ecosistemas del Salar de Atacama


Biotecnología
Ecosistemas del Salar de Atacama
Cuando se habla de biología o ciencia en general, solemos pensar que es algo muy lejano, que sólo se encuentra en los lagos, bosques, animales, etc., pero son pocas las personas que podrían esperarse o imaginar que el color verde del maquillaje de las madres, se creó gracias a pigmentos presentes en microorganismos del Salar de Atacama, específicamente, ¡en algas!

Cuando se habla de biología o ciencia en general, solemos pensar que es algo muy lejano, que sólo se encuentra en los lagos, bosques, animales, etc., pero son pocas las personas que podrían esperarse o imaginar que el color verde del maquillaje de las madres, se creó gracias a pigmentos presentes en microorganismos del Salar de Atacama, específicamente, ¡en algas!

Biotecnología
Ecosistemas del Salar de Atacama

¿Por qué son útiles los microorganismos para la salud o el medio ambiente?
Biotecnología
Ecosistemas del Salar de Atacama


La microbiota existente en el Salar de Atacama son interesantes, no sólo por las condiciones extremas a las que se adaptan, sino también para saber cómo se desarrollan y funcionan sus metabolismos bajo condiciones de estrés como salinidad, temperaturas extremas y radiación solar.
De ambientes como estos, se han aislado bacterias, arqueas y microalgas de interés biotecnológico y científico por su resistencia al estrés ambiental y la producción de compuestos bioactivos, que podrían potencialmente usarse en áreas como la salud o el medio ambiente.
Biotecnología
Ecosistemas del Salar de Atacama
¿En qué áreas se pueden usar los microorganismos del Salar de Atacama?
Biotecnología
Ecosistemas del Salar de Atacama


Se han descubierto diversos usos de los microorganismos y sus compuestos para distintas áreas:
- Salud: Algunas bacterias y algas producen sustancias que pueden ser usadas en la medicina como inhibidores de colesterol o compuestos microbianos. Las microalgas pueden usarse como suplementos nutricionales, pueden llegar a producir antioxidantes, también pueden ser usadas para crear proteínas terapéuticas y vacunas.
- Alimentación animal: Las microalgas resultan ser una buena fuente nutritiva para la acuicultura y para alimentos de mascotas.
- Pigmentos: Los pigmentos de los microorganismos pueden usarse para alimentos, cosméticos y otros productos farmacéuticos, también tienen propiedades antioxidantes.
- Biofertilizantes: Pueden usarse los microorganismos para reducir el uso de fertilizantes químicos que contaminan.
- Bioprocesamiento de metales: Es posible que se puedan extraer metales de minerales o desechos usando microorganismos.
- Fuentes alternativas de energía: Algunas microalgas pueden utilizarse como biocombustible gracias a su alto contenido de lípidos.
Biotecnología
Ecosistemas del Salar de Atacama

¿No que los microorganismos causaban enfermedades?
Biotecnología
Ecosistemas del Salar de Atacama


La verdad es que popularmente, los microorganismos son conocidos como causantes de enfermedad, pero también hay muchos que pueden funcionar como una alternativa para procedimientos de salud, para ser más amigable con el medioambiente, producir toxinas para industrias, etc. Todo gracias a entender que estos organismos únicos permiten ver el desarrollo de la vida en diferentes condiciones, y así, poder descubrir usos para hacer las actividades productivas más sustentables.
Biotecnología
Ecosistemas del Salar de Atacama

Trivia
Para que científicos y científicas utilicen los microorganismos del salar, deben lograr cultivarlos en laboratorio y que, durante su crecimiento, realicen varios procesos químicos conocidos como “metabolismo”, a partir del cual se forman y acumulan diversas moléculas que son utilizadas por los microorganismos para diversas funciones. Entre estas moléculas, están las proteínas, compuestos de azufre, pigmentos, nitrógeno, etc., los que se pueden extraer y utilizar para diversos usos industriales. Así mismo, las personas también hacemos “metabolismo” cuando comemos alimentos o bebidas y lo transformamos en energía, como cuando comes mucha azúcar y no paras de correr o, al revés, cuando no has comido en un buen rato y no tienes ganas de nada.
Biotecnología
Ecosistemas del Salar de Atacama

Científicamente hablando...
La vida en el Salar de Atacama se caracteriza por la capacidad de adaptación de los microorganismos a condiciones extremas, ofreciendo valiosas oportunidades para comprender los procesos metabólicos bajo situaciones de estrés. Estos organismos, como bacterias, arqueas y microalgas, han demostrado resistencia y capacidad para producir compuestos bioactivos de interés científico y biotecnológico, con aplicaciones en salud, agricultura, bioprocesamiento de metales y energía alternativa. Destacan hallazgos como Llayta, una cianobacteria con potencial alimenticio y medicinal; bacterias como Streptomyces asenjonii con propiedades antimicrobianas; y microalgas como Chlorella sorokiniana, ricas en proteínas y lípidos, utilizadas en nutrición humana y animal, así como en la producción de biocombustibles. Estos microorganismos también son importantes para la bioremediación ambiental y el desarrollo de terapias contra el cáncer. La investigación en estos ecosistemas extremos ofrece perspectivas prometedoras para la producción sostenible de recursos y la preservación del medio ambiente, representando un potencial crucial en diversos campos científicos y tecnológicos.
Biotecnología
Ecosistemas del Salar de Atacama

MRDH
Fuente
- Harver, N. (2013). Hidden Beauty: Exploring the Aesthetics of Medical Science. Schiffer.
- Hayashida, G. (2016). Efecto de temperatura y nitrógeno sobre la síntesis de proteínas vinculadas a las vías metabólicas de ácidos grasos, en Nannochloropsis gaditana CCMP-527 y Chlorella sp. CH03. Tesis Doctoral, Programa de Doctorado en Ciencias Biológicas Mención Biología Celular y Molecular, Facultad de Ciencias de la Salud. Universidad de Antofagasta.
- Hayashida, G. (2016). Efecto de temperatura y nitrógeno sobre la síntesis de proteínas vinculadas a las vías metabólicas de ácidos grasos, en Nannochloropsis gaditana CCMP-527 y Chlorella sp. CH03. Tesis Doctoral, Programa de Doctorado en Ciencias Biológicas Mención Biología Celular y Molecular, Facultad de Ciencias de la Salud. Universidad de Antofagasta.
- El Mostrador Cultura (2021). Descubren bacteria con potencial biotecnológico en el desierto de Atacama. El Mostrador.
- Vera-López Portillo, F. y Martínez Jiménez, A. (2021). Pigmentos en microalgas: funciones, aplicaciones y técnicas de sobreproducción. Bio Tecnología, 25(5): 35-51.
- Girgis, M. (2020). Implications of a Changing Ecosystem: The Effect of Environment and Life Stage on Brine Shrimp. Minor in Sustainability, College of Science, University of Notre Dame.
- Mendoza, H., De la Jara, A. y E. Portillo (2011). Planta piloto de cultivo de microalgas. Instituto Tecnológico de Canarias.